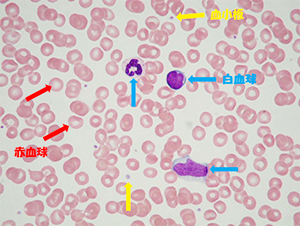
写真

検体検査課
業務紹介
生化学検査
採血時から、患者さんの検体はすべてバーコードで管理をしています。また、患者さん毎に検査結果を時系列で管理し、個々のデータ変動を確認した上で報告しています。 異なる種類の分析でも、一度に大量の検体が迅速かつ正確にデータ化されるため、当日の診察や治療の現場にデータを届ける事ができます。 同一分析装置を複数機稼働させているため、メンテナンスや試薬入れ替え時でも測定でき、24時間対応で検査をしています。 生化学免疫検査では、特に血清(血液中の赤血球や白血球などを除いた)成分や尿などを用いて検査を行っております。 生化学検査では、56項目(下表)の検査を自動分析装置で1時間に4000テスト処理することができます。
日立自動分析装置 LABOSPECT 008

主な測定項目
| TP | Ca | T-Bil | LAP | CRP | グリコアルブミン | 不飽和鉄結合能 |
| ALB | IP | D-Bil | CK | KL-6 | 3ヒドロキシ酪酸 | 総鉄結合能 |
| UN | Mg | ALP | AMY | 補体価 | 総ケトン体 | テイコプラニン |
| UA | T-Cho | ChE | LIP | IgG | プレアルブミン | 尿蛋白 |
| CRE | HDL-C | γ-GT | Fe | IgA | トランスフェリン | 微量アルブミン |
| Na | LDL-C | AST | Zn | IgM | レチノール結合蛋白 | 抗ストレプトリジンO抗体価 |
| K | TG | ALT | Glu | C3 | 梅毒血清反応 | エタノール |
| Cl | ZTT | LD | NH3 | C4 | 梅毒抗体 | リウマチ因子 |
グリコヘモグロビン分析装置 アダムスA1c HA-8181

免疫検査
全自動化学発光免疫測定装置ARCHITECT i2000SR
免疫検査のARCHITECTでは、B型肝炎ウイルス、C型肝炎ウイルスなどの感染症や抗てんかん薬や抗菌剤などの各種血中薬物濃度の測定など計27項目(下表)を測定しています。 1時間に200テスト処理することができます。
主な測定項目
| AFP | HBs抗原 | CK-MB |
| CEA | HBs抗体 | トロポニンI |
| CA19-9 | HBc抗体 | テオフィリン |
| SCC | HBe抗原 | バンコマイシン |
| CYFRA | HBe抗体 | フェニトイン |
| CA125 | HCV抗体 | フェノバルビタール |
| CA15-3 | HIV | バルプロ酸 |
| PSA | HTLV | カルバマゼピン |
| Free PSA | BNP | ジゴキシン |
全自動電気化学発光免疫測定装置cobas 6000
cobas6000では、FT3、FT4、TSHなどの甲状腺項目や、ACTHやコルチゾールのホルモン検査など計16項目(下表)を測定しています。 1時間に170テスト処理することができます。
全自動化学発光酵素免疫測定装置 SphereLight
Sphere Lightでは、インスリンやC-ペプチドの糖尿病検査項目やピロリ菌抗体検査など計10項目(下表)を行っています。 1時間に180テスト処理することができます。
血液検査
人間の血液は、血球と呼ばれる有形成分と血漿と呼ばれる液体成分で構成されています。血球には白血球・赤血球・血小板等が含まれており、その成分数や形態を調べることで、主に血液疾患の診断や治療効果の判定に役立っています。また、血漿を用いて血液の凝固機能を調べる検査も実施しています。
できるだけ迅速に結果を報告するため、ほとんどの検査項目は自動分析装置で測定しています。

多項目自動血球分析装置
XE-AlphaN(XE-5000/SP10)

血球分析装置
UniCel DxH 800、ACT・diff
血球算定検査
下記項目を自動血球分析装置で測定しています。
| 略号 | 検査項目名 | 検査結果の説明 |
|---|---|---|
| WBC | 白血球数 | 感染症などの炎症性疾患、白血病などの血液疾患で異常値を示します。また、薬剤の影響も反映します。 |
| RBC | 赤血球数 | 貧血や多血症を推測することができます。 |
| HGB | 血色素量 | |
| HCT | ヘマトクリット | |
| MCV | 平均赤血容積 | 貧血の鑑別に用いられます。 |
| MCH | 平均赤血球血色素量 | |
| MCHC | 平均赤血球血色素濃度 | |
| PLT | 血小板数 | 出血傾向がある場合に、その原因を探索するための検査の一つです。 |
| RET | 網赤血球数 | 骨髄での赤血球の産生状態を表します。 |
血液像検査
白血球に関しては、その数値だけでなく細胞分類の比率も大切です。臨床検査技師が、作製した血液塗抹標本を顕微鏡で目視し、細胞分類(5種類:好中球、リンパ球、単球、好酸球、好塩基球)や個々の細胞形態に異常がないかを確認しています。
*塗抹標本とは、スライドガラスに血液を薄く塗りつけて染色したものです。
| 略号 | 検査項目名 | 検査結果の説明 |
|---|---|---|
| Neutrophil | 好中球 | 細菌などの異物を取り込んで消化・殺菌して異物から身体を守る働きをしています。 |
| Eosinophil | 好酸球 | 寄生虫に対する生体防御機能を持ち、様々なアレルギー反応に関与しています。 |
| Basophil | 好塩基球 | 様々なアレルギー反応に関与しています。 |
| Lymphocyte | リンパ球 | 免役反応の中心的役割を担っています。 |
| Monocyte | 単球 | 好中球と同様の働きを持ち、異物から身体を守る働きをしています。 |
凝固・線溶検査
止血・血栓に関する項目を自動血液凝固分析装置で測定しています。
*凝固:血が固まること。線溶:血液の固まりが溶けること。

血液凝固分析装置 コアプレスタ®2000
| 略号 | 検査項目名 | 検査結果の説明 |
|---|---|---|
| PT(sec) | プロトロンビン時間(秒) | 出血傾向のスクリーニングとして用いられます。他には、肝疾患の進行程度の診断、ワルファリンなどの経口抗凝固療法のモニタリングとしても用いられます。 |
| PT(%) | プロトロンビン時間(活性) | |
| PT(INR) | プロトロンビン時間(標準比) | |
| APTT | 活性化部分トロンボプラスチン時間 | 出血傾向のスクリーニングとして用いられます。血友病の診断にも必要な検査です。 |
| TTO | トロンボテスト | 血液の凝固する力がどの程度かを調べます。 |
| FBG | フィブリノゲン | 急性炎症や、悪性腫瘍などで増加します。 |
| ATⅢ | アンチトロンビンⅢ | 肝疾患、血栓症、ヘパリン療法時などに検査します。 |
| DD | Dダイマー | 生成された血栓を溶解する線維素溶解(線溶)に関する検査です。 |
細菌検査
感染症は、ウイルスや細菌をはじめとする多種多様な病原微生物によって引き起こされ、微熱や下痢、咳、発疹などの様々な症状がでる病気です。
細菌検査室では、患者さまから採取した検体(喀痰、尿、便、血液など)の中に感染症の原因となる細菌がいるかどうか、またその細菌に効く抗菌薬は何であるかを調べる検査を行っています。
検査の流れとしては、まず検査材料をスライドガラス(ガラス板)に塗り、色素を使い染色して細菌の有無や量、形態などを光学顕微鏡で観察します。そして検査材料を培養し、肉眼で観察できる菌のかたまりに育てて、大きさや形、色、においなどを観察し、培養検査で発育した菌の名前(性質)を調べるために性状を確認します。
近年注目されている新しい検査法として、迅速同定機器を用いた迅速同定検査があり、当院細菌検査室ではこの迅速同定機器を使用して、通常18~24時間かかる検査を5分で行えることから、一日早く病原細菌の同定結果を報告しています。同定後、薬剤感受性検査を行います。感染症の治療用に、数多くの抗生物質がありますが、残念ながら全ての細菌に効くという万能の抗生剤はありません。そのため、検出された細菌ごとに効果のある抗生剤を調べる必要があります。
これらを総合して、患者さまの治療に直結する検査結果を主治医に報告することで、感染症診断の一躍を担っています。

全自動微生物検査システム
マイクロスキャンWalkAway

微生物分類同定分析装置
MALDI バイオタイパー

PCR検査用核酸増幅・検出装置
「コバス TaqMan 48」
また、迅速検査として以下の項目を行っており、約5~30分で検査報告が可能です。
| 検査項目名 | 検査材料 |
|---|---|
| インフルエンザウイルス抗原 | 鼻腔拭い液 咽頭拭い液 |
| RSウイルス抗原 | |
| アデノウイルス抗原 | |
| A群溶連菌抗原 | |
| マイコプラズマニューモニエ抗原 | |
| 肺炎球菌抗原 | 尿 |
| レジオネラ抗原 | |
| ロタ・アデノウイルス抗原 | 便 |
| ノロウイルス抗原 | |
| O157抗原 | |
| クロストリディウムディフィシルAB抗原 |
さらに、院内感染対策チーム(ICT:Infection control team)および抗菌薬適正使用支援チーム(AST:Antimicrobial Stewardship Team)に所属しております。医師、看護師、薬剤師などと連携を取り、検査材料から検出された病原菌情報を管理・発信し、散発例や病院内集団発生の監視、抗菌薬の適正使用に努めています。
輸血センター
血液の病気や抗がん剤などの薬の影響で、十分に血液を作ることができなくなったり、事故や手術などで大量出血したとき輸血が必要となります。
輸血せずに放置しておくと、息切れや動悸、めまいなどが起こったり、出血が止まらず最悪の場合、生命に危険がおよぶこともあります。これらの症状の改善が必要な時に輸血します。輸血検査室では、健常者の皆さんが献血してくださった血液製剤を、輸血を必要とする患者さんが安心して輸血治療を受けられるように、血液型検査や献血された血液製剤が輸血を受ける患者さんに適合しているか等、検査をしています。
輸血についての説明と同意
輸血を行う際には、輸血前に主治医が患者さんに、輸血の必要性や有効性、使用する輸血用製剤の種類や量、輸血に伴うリスク等について説明し、同意を得ます。
血液型を確かめる検査
・ABO血液型検査
血液型は大きくA型、O型、B型、AB型に分けられます。
・Rh血液型検査
ABO血液型と同様に重要な血液型で、Rh抗原の中でも特に、D抗原がある場合をRh陽性、D抗原がない場合をRh陰性と言います。日本人のRh陰性の割合は約0.5%(200人に1人)です。
・不規則抗体検査
ヒトの赤血球には、ABO血液型やRh血液型以外にもたくさんの種類の血液型があり、全く同じ血液型の血液を輸血する事はほとんど不可能です。
妊娠や輸血などにより、自分とは異なる血液が身体の中に入ると、その血液に反応する抗体がつくられることがあり、これを不規則抗体と呼びます。患者さんの血液中に不規則抗体があると、輸血した血液を壊すなど副作用を起こすことがあるため、不規則抗体の有無を事前に検査します。
全自動輸血検査システム オーソ ビジョン

交差適合試験
患者さんが不規則抗体を持っていると、輸血用血液製剤と反応し、副作用を起こすことがあります。このような副作用を未然に防ぐため、患者さんの血液と輸血用血液製剤が 適合するかを検査します。
〈感染症の検査〉
輸血後に輸血による感染症が疑われたときのために、輸血前にあらかじめ感染症の検査を行ったり、あとで確認の検査ができるように患者さんの血液を保管したりしています。
〈輸血の実施〉
輸血用製剤の受け渡し時や、輸血を実施する際には、「患者氏名」「血液型」「必要血液の種類と単位数」などを、複数名でしっかりと確認し、輸血を実施します。